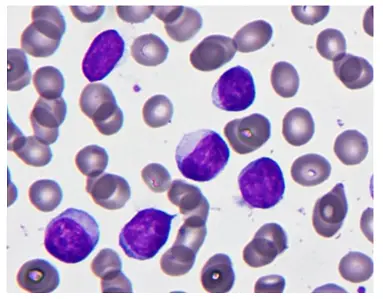
圖片描述

111年:(醫檢)血液(2)
60歲男性一直身體感覺良好。但最近首次健檢卻發現白血球高達 32,000/μL ,其中淋巴球比例高達 75% 。周邊血液抹片如圖示,則這些淋巴球的細胞表面標記最可能為下列何者?
ACD19+/CD5-/CD23-/CD10-
BCD19+/CD5+/CD23-/CD10+
CCD19+/CD5+/CD23+/CD10-
DCD19+/CD5+/CD23+/CD10+
詳細解析
本題觀念:
此題聚焦於慢性淋巴球性白血病(Chronic Lymphocytic Leukemia, CLL)的典型免疫表型判讀,並與其他 B 細胞淋巴腫瘤(如 mantle cell lymphoma、follicular lymphoma)區別診斷。
影像分析:
外周血抹片可見大量大小均一的小淋巴球,細胞核呈顆粒狀染色質(clumped chromatin),胞質稀少,偶見破碎細胞(smudge cells)。這種小而成熟的淋巴球浸潤血液典型於 CLL,而非急性白血病的細胞質豐富或顆粒變化,亦非成熟淋巴漿細胞樣(plasmacytoid)多形性表現。
選項分析
- 選項A (CD19+/CD5–/CD23–/CD10–):僅有 B 細胞標記 CD19,缺乏 CLL 的 CD5 與 CD23 表達,不符合 CLL 免疫表型,排除。
- 選項B (CD19+/CD5+/CD23–/CD10+):雖有 CD5+,但 CD23–、CD10+ 與 follicular lymphoma 的表型更吻合,不符 CLL,排除。
- 選項C (CD19+/CD5+/CD23+/CD10–):典型 CLL 同時表達 CD5、CD23,且不表達 CD10,最符合診斷 ([pubmed.ncbi.nlm.nih.gov](https://pubmed.ncbi.nlm.ni
...(解析預覽)...

升級 VIP 解鎖圖文解析